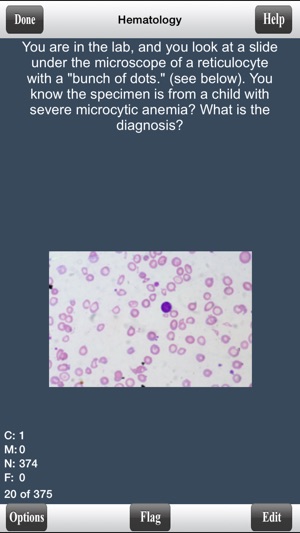

價格:免費
更新日期:2016-01-15
檔案大小:29.6 MB
目前版本:2.42
版本需求:需要 iOS 6.0 或以上版本。與 iPhone、iPad 及 iPod touch 相容。
支援語言:英語

This is a fully functional version of COMLEX Level 1 Flashcards. It has only a few select cards for your evaluation. However, all options and features are active.
This is the Lite version for COMLEX Level 1 Pathology Flashcards. The full version has over 3000 different COMLEX Level 1 to master the material to do well on the COMLEX exam to get the residency of your choice.
The program itself offers various features and options for a great and convenient learning environment which include:
- Ability to Randomize cards
- Can Flag cards for later use

- Grade cards by using gestures
- Study only missed cards, only new cards, only correct cards, flagged cards, or study all cards
- Study all categories or selected categories
- Timed mode to automatically flip card and advance cards.
- Ability to edit and delete cards

- Convenient statistics panel to see progress
- Can change background color and text color
- Can change text size
- Can see back of card first
If you enjoy our Lite version, you can purchase our full version on the app store.
Try it out!

支援平台:iPhone, iPad
